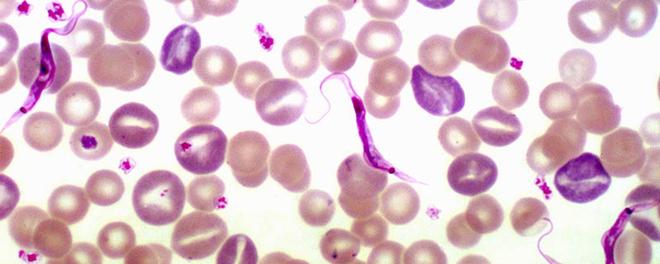

寄生虫是什么东西
寄生虫是一种具有致病性的低等真核生物。
寄生虫不仅可以作为一种病原体,还可以作为一种媒介传播疾病。寄生虫的特征是在宿主或者是寄主体内或者是附着于体外以获取维持其生存、发育以及繁殖所需的营养或者是庇护的一切生物。很多小动物以寄生的方式生存,并依附在比它们更大的动物身上。

寄生虫是能够改变寄主的行为,从而达到自身更好的繁殖生存。有些寄生虫会为了寄生生活而发展出来的器官,像猪肉绦虫的新皮,带钩以及吸盘的头节,退化的肠,节片繁殖以及水蛭的吸盘;再或者是寄生虫形态的变化,像Csndiru吸血后身体就会膨胀起来。
以上是 寄生虫是什么东西 的全部内容,来自【游乐园】,转载请标明出处!

